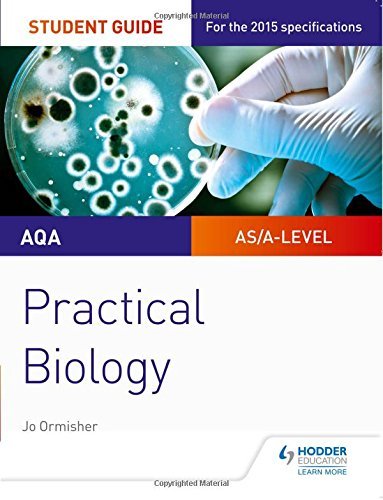

Save 10% On This Item as a Thryft Club Member
Join Thryft Club for S$30/year and enjoy 10% off everything, plus S$10 off your first order. Join now →
We will send you an email to reset your password.
Comprehensive guide for AQA Biology practicals.
If you're tackling A-Level Biology with AQA, this Student Guide could be invaluable. It doesn't just list practicals—it teaches you how to analyze them and hone your exam technique, almost like having a tutor guide you through the nuances of a lab. The summaries, questions, and exam tips are geared towards building a solid understanding that can help boost your grades. Plus, with answers provided, it's like instant feedback on your progress.
This book may contain very minor cosmetic defects, but it is in pristine condition. There should be no yellowing, no foxing, no water damage, and no annotations of any kind on the cover and the pages. For paperbacks, there should not be any crease marks on the spine. This book is good as new — lucky you!
*Books may be missing bundle media (e.g. CD, e-book code), if included.
This book has been used, but it is still in a clean condition. There should be no foxing or annotations of any kind on the inner pages, but a sparse amount may be present on the cover, title pages, or outside edges of the book. There should be no water damage of any kind. For paperbacks, there may be light crease marks on the spine.
*Books may be missing bundle media (e.g. CD, e-book code), if included.
We do our best to ensure the quality of our books, but there is no escaping the wear and tear that comes with time. Slight foxing and some annotations may be present on the pages and the cover. There should be no water damage of any kind. For paperbacks, there may be several crease marks on the spine.
*Books may be missing bundle media (e.g. CD, e-book code), if included.
This is a well-read book, which means that the previous owner probably really enjoyed it! The cover and pages may include moderate foxing and annotations, but the text is not obscured and still readable. Moderate cosmetic defects and minor water damage may be present on the edges of the book. For paperbacks, there may be multiple crease marks on the spine.
*Books may be missing bundle media (e.g. CD, e-book code), if included.
Find out more about our process here.
Join Thryft Club for S$30/year and enjoy 10% off everything, plus S$10 off your first order. Join now →
Adding product to your cart
Comprehensive guide for AQA Biology practicals.
If you're tackling A-Level Biology with AQA, this Student Guide could be invaluable. It doesn't just list practicals—it teaches you how to analyze them and hone your exam technique, almost like having a tutor guide you through the nuances of a lab. The summaries, questions, and exam tips are geared towards building a solid understanding that can help boost your grades. Plus, with answers provided, it's like instant feedback on your progress.
Enter our giveaways, keep up with our latest sales and events, and receive recommendations direct to your inbox. We'll only send the good stuff, promise!
By completing this form, you are signing up to receive our emails and can unsubscribe at any time.